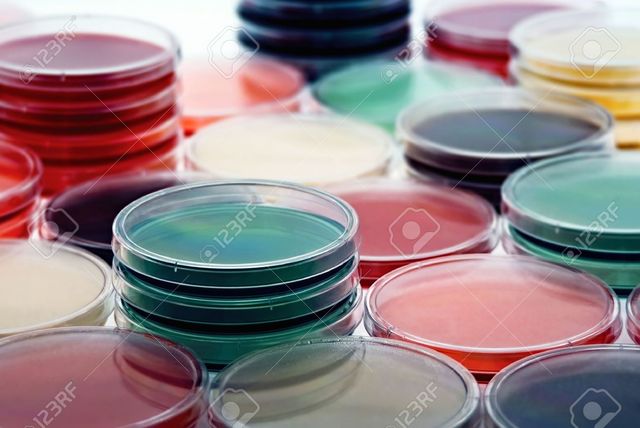
Primeros medios de cultivo

-
El Consejo Nacional de la Enseñanza y del Ejercicio Profesional de las Ciencias Químicas (CONAECQ) reacreditó y distinguió la alta calidad académica de los programas de Químico Bacteriólogo Parasitólogo y Licenciado en Ciencias de los Alimentos de la Facultad de Ciencias Biológicas de la Universidad Autónoma de Nuevo León.
-
Se inicia un proyecto que busca la acreditación internacional. Por tal motivo, se modifican los planes de estudio, según los lineamientos del Texas Internacional Educational Consortium (TIEC), con un modelo de nueve semestres y un promedio de 40 a 45 asignaturas.
-
El plan de estudios de Biólogo Bacteriólogo Parasitólogo, se modifica en 1968 y da lugar a la carrera de Químico Bacteriólogo Parasitólogo.
-
El Colegio de Químicos Bacteriólogos Parasitólogos de Nuevo León, es una Asociación Civil con propósitos no lucrativos, que fue fundado por un grupo de profesores y egresados de la Facultad de Ciencias Biológicas de la U.A.N.L. el 22 de Octubre de 1981, para trabajar en beneficio de la sociedad y de la profesión.
-
La Escuela de Ciencias Biológicas nace el 19 de septiembre de 1952 bajo el amparo del Instituto de Investigaciones Científicas de la. Facultad de Filosofía, Ciencias y Letras de la Universidad de Nuevo León. Su fundador fue el Dr. Eduardo Aguirre Pequeño.
-
Se puede decir que la historia de los antibióticos como tal comienza en 1928, cuando un científico británico llamado Alexander Fleming, descubrió la penicilina.
-
La Escuela Nacional de Medicina abre por primera ves la especialidad de bacteriología y anatomía patológica.
-
Hoy, la técnica de Tinción Gram, desarrollada por Christian Gram, es la más utilizada en los laboratorios de bacteriología y microbiología y permite, de acuerdo con la estructura y grosor de la pared bacteriana, agrupar las bacterias en Gram positivas y Gram negativas.
-
Para perfeccionar el conocimiento que se requería sobre las bacterias, Robert Koch desarrolló un método para reproducirlas en un medio de cultivo sólido hecho con gelatina, e introdujo el método de la placa para asegurar cultivos puros. El uso de un medio sólido fue una idea nueva, ya que hasta esa época se habían empleado casi exclusivamente infusiones vegetales y otros líquidos, lo que facilitó la obtención de cultivos puros de bacterias para su estudio individual.
-
Mendeléyev acomodó los 66 elementos conocidos en ese momento en su tabla periódica por orden creciente de peso atómico, pero también atendiendo a sus propiedades, y acertó al dejar huecos en la tabla para elementos todavía no descubiertos.
-
Ehrenberg utilizó el nombre de "bacteria" que deriva del griego βακτήριον -α, bacterion -a que significa bastón pequeño
-
La primera vacuna que se empleó en la profilaxis de las enfermedades infecciosas fue la de la viruela y su descubrimiento se debe a Edward Jenner.
-
Descubrimiento del primer parásito Leeuwenhoek, obtuvo más créditos y fue nombrado el "padre de la protozoología y parasitología" al descubrir el primer protozoo parásito cuando observó en su propia diarrea grandes poblaciones de Giardia Lamblia.
-
El holandés Antoni Van Leeuvenhoek fabricó sus propios microscopios simples, que lo llevaron al descubrimiento de los glóbulos rojos en 1673, así como también al descubrimiento de las bacterias y del esperma humano.
-
Robert Hooke publico su libro micrographia publicó el libro Micrographía, el relato de 50 observaciones microscópicas y telescópicas con detallados dibujos. Este libro contiene por primera vez la palabra célula.
-
El inglés Robert Hooke creó el primer microscopio compuesto, en el cual se utilizaban dos sistemas de lentes, las lentes oculares (u ocular) para visualizar y las lentes objetivos
-
El microscopio fue inventado por un fabricante de anteojos de origen holandés, llamado Zaccharias Janssen
Plan projects on a visual timeline
Map milestones, phases, deadlines, and key events in one place so the sequence is easier to see and share. Timetoast is a timeline maker for work, school, research, and stories.